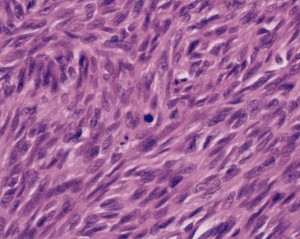

Leiomyosarcoma Definition
Page Contents
Leiomyosarcoma (LMS) is a malignant cancer of the smooth muscle cells. This is a rare type of tumor that is most frequently found to arise in the abdomen or the uterus.
Leiomyosarcoma Incidence
Soft tissue carcinomas arise in one out of every 100 cases of cancer. LMS is categorized as a carcinoma of the soft tissue. Most individuals affected by LMS are above 50 years of age.
Leiomyosarcoma ICD 10 Code
The ICD 10 Code for this condition is 49.
Leiomyosarcoma Symptoms
LMS may develop in almost any area of the body that contains smooth muscle. This includes regions such as:
Picture 1 – Leiomyosarcoma
- Heart
- Blood vessels
- Liver
- Skin
- Uterus
- Gastrointestinal tract
- Genitourinary tract
- Retroperitoneum or the space lying behind the abdominal cavity
The uterus is the commonest spot for the development of this type of malignant tumor. The condition also commonly affects the liver. When the liver is involved, patients experience problems like jaundice and enlargement of the liver.
The majority of LMS tumors of the gastrointestinal tract are now reclassified as GIST (Gastrointestinal Stromal Tumors).
The various types of cancer, including LMS, can be classified on the basis of the following factors:
- The type of cell that is involved
- The clinical course of the disorder
- The particular nature of the malignancy
In the early stages of LMS, affected individuals are usually asymptomatic. In other words, they do not display any signs or symptoms. Most LMS tumors are detected once a patient starts exhibit symptoms associated to this condition. These may include:
- Bloated sensation or abdominal discomfort
- Pain or inflammation in any region of the body
- Swelling or development of lumps
- Obstruction of the hepatic vein
- Aches and presence of fluid in the abdominal cavity
- Inflammation of the legs
- Vaginal bleeding in menopausal women or change in periods in non-menopausal females
Those experiencing one or more of the above mentioned problems should get in touch with a general practitioner. However, it is important to remember that these problems may also arise due to many other disorders or underlying conditions.
Knowledge of having this type of growths may also give rise to various psychological issues like:
- Anger
- Fear
- Anxiety
- Guilt
- Resentment
These are normal reactions and friends and family members of sufferers should try to help them cope with such issues. In difficult cases, professional psychological assistance may be required.
Types of Leiomyosarcoma
According to the location of their growth, LMS tumors are classified into:
Uterine LMS
It is a rare type of malignant growth arising from the smooth muscular lining of the uterine lining (myometrium).
Cutaneous LMS
These arise from the pilo-erector muscles present in the skin.
Gastrointestinal LMS
These can arise from the smooth muscle in the gastrointestinal tract or from a blood vessel.
Leiomyosarcoma Causes
It is not exactly known why this type of tumor arises. Research is still to determine the exact reason for the origin and development of this cancerous growth.
Certain factors have, however, been considered to be the possible causes of this disorder. These include:
Radiotherapy
In extremely rare cases, sarcomas of the soft tissue may occur in regions that have been treated with radiotherapy any time earlier for any other type of cancer. However, the sarcomas do not usually arise until approximately 10 years after this type of treatment.
Chemical exposure
Exposure to some types of chemicals may elevate the susceptibility of an individual to certain types of sarcomas. Such groups of chemicals include dioxins, some forms of weed-destroyers or herbicides or vinyl chloride (used for manufacturing plastics).
Leiomyosarcoma Diagnosis
As it is often asymptomatic in the initial stages, LMS is often difficult to diagnose early on. With its progression, the disorder begins to exhibit problems like swelling and discomfort which leads to its detection.
Patients of LMS usually turn to general practitioners for medical guidance, who in turn refer them to hospital specialists. In hospital, diagnosis begins by a thorough analysis of the medical history of sufferers. Physical examination and blood tests are also used for the purpose of detection and checking the general health condition of affected individuals.
Depending on the part of the body that is being investigated, various diagnostic tests may be used. These include:
Hysteroscopy
It is used to detect clinical issues in the womb. In this exam, physicians use hysteroscope (a thin, small tube with a camera and a light fitted at the end) to take a view of the womb and extract tissue samples for microscopic analysis. The instrument is passed into the womb through the vagina. The test may be used as an outpatient procedure under the effects of a local anesthetic. Sometimes, however, use of a general anesthetic is needed.
Although it might be uncomfortable, the process is not painful. However, some women may suffer from cramps during the process and even for a few days after the test. The cramps are mild in intensity.
Endoscopy
It is the most common tests used for the detection of clinical issues in the gullet (oesophagus) and the stomach. Patients need to be on an empty stomach before the process is conducted. They must nit drink or eat anything for at least 4 hours prior to the exam. Following a sedative administration into the vein of an arm of the affected person, a local anesthetic is injected onto the back of the throat. This is followed by the insertion of an endoscope (a flexible tubular structure with a lens and a light fitted at the end) down the oesophagus and into the stomach.
MRI (Magnetic Resonance Imaging) Scan
The process is similar to CT scan. However, it involves the use of magnetism instead of x-rays to render cross-sectional images of the body. During the process, patients are asked to lie absolutely still on a couch located within a large, open-ended metallic cylinder. The test may take around an hour to be conducted.
The exam involves production of loud noise, which might be difficult for some patients to bear. Due to this reason, sufferers are provided with headphones or earplugs to wear during the test. They are able to interact with the person in charge of the scanner.
It is noteworthy that people fitted with pacemakers, surgical clips or metal in the eyes will not be able to undergo this exam.
CT (Computerized Tomography) Scan
The exam involves taking a series of x-rays that create 3D images of the internal structures of the body. It includes use of small amounts of radiation which is least likely to harm individuals undergoing this process. As in Endoscopy, patients are advised not to consume any solid or liquid substance from at least 4 hours prior to the actual time of the scan. Individuals are typically injected with a dye that allows clearer view of specific areas of the body. The injection may make patients experience a hot sensation. Sufferers should consult doctors if they are asthmatic or allergic to iodine. Otherwise, they could suffer from serious reactions due to the dye injection.
Ultrasound scan
In this test, audio waves are used to render images of the abdomen and its adjoining regions. Patients are asked not to consume anything solid. They are, however, permitted to drink liquids (although only clear fluids and nothing viscous or fizzy) 4-6 hours prior to the scan.
During the actual process, patients are asked to lie on their back comfortably. A gel is spread over their abdomen and a probe (a tiny device shaped like a microphone) is rubbed over this. The probe emits audio waves that are afterwards converted into images rendered into a computer screen. In some cases, the probe is inserted slowly into the vagina to let physicians have a closer view of the womb.
The test is not painful. It takes around 15-20 minutes to perform this examination. The exam is typically conducted in the scanning department of hospitals.
Biopsy
It includes taking tissue strips or some cells from the affected region for microscopic analysis. Once the area is made numb by injecting a local anesthetic, a fine needle is inserted through its overlying skin and into the tumor.
Leiomyosarcoma Treatment
The treatment for this disorder depends on a number of factors. These include:
Picture 2 – Leiomyosarcoma Image
- General health status of sufferers
- Size of tumor within the body
- Location of tumor inside the body
The results of diagnostic tests conducted for this disorder help physicians decide on the best treatment option for sufferers. Doctors discuss with patients about the treatment measure that is most suitable for them.
The curative options for this tumor include:
Surgery
It is the most common treatment option used for curing LMS by removing the malignant growths. Radiotherapy may be used as a follow-up measure to lower the risk of recurrence of this cancerous condition.
Chemotherapy
It is used for treating some cases of LMS. The process may either be used for curing an LMS that has spread to other regions of the body or for lowering the risk of recurrence of the growth.
Leiomyosarcoma Survival Rate
The outcome of LMS is not a good one. The condition usually has an unfavorable prognosis with the survival rate being less than 3-5 years in duration. This is due to the high risk of recurrence and metastasis associated with these form of malignant growths.
Leiomyosarcoma Support Groups and Organizations
Individuals affected by LMS may seek general advice and information from the following organizations:
Northwest Sarcoma Foundation
P.O. Box 91460
Portland, OR 97291
Tel: (503)954-5740
Email: [email protected]
Internet: http://www.nwsarcoma.org
Rare Cancer Alliance
1649 North Pacana Way
Green Valley, AZ 85614
USA
Tel: (520)625-5495
Fax: (615)526-4921
Internet: http://www.rare-cancer.org
National Cancer Institute
6116 Executive Blvd
MSC 8322
Room 3036A
Bethesda, MD 20892-8322
USA
Tel: (301)435-3848
Tel: (800)422-6237
TDD: (800)332-8615
Email: [email protected]
Internet: http://www.cancer.gov
American Cancer Society, Inc.
1599 Clifton Road NE
Atlanta, GA 30329
USA
Tel: (404)320-3333
Tel: (800)227-2345
TDD: (866)228-4327
Internet: http://www.cancer.org
Those experiencing the symptoms of LMS should seek medical attention at the earliest. This being a malignant condition, it is important not to delay treatment and seek professional medical care at the earliest stage to prevent later complications.
References:
http://www.webmd.com/cancer/leiomyosarcoma-general
http://en.wikipedia.org/wiki/Leiomyosarcoma